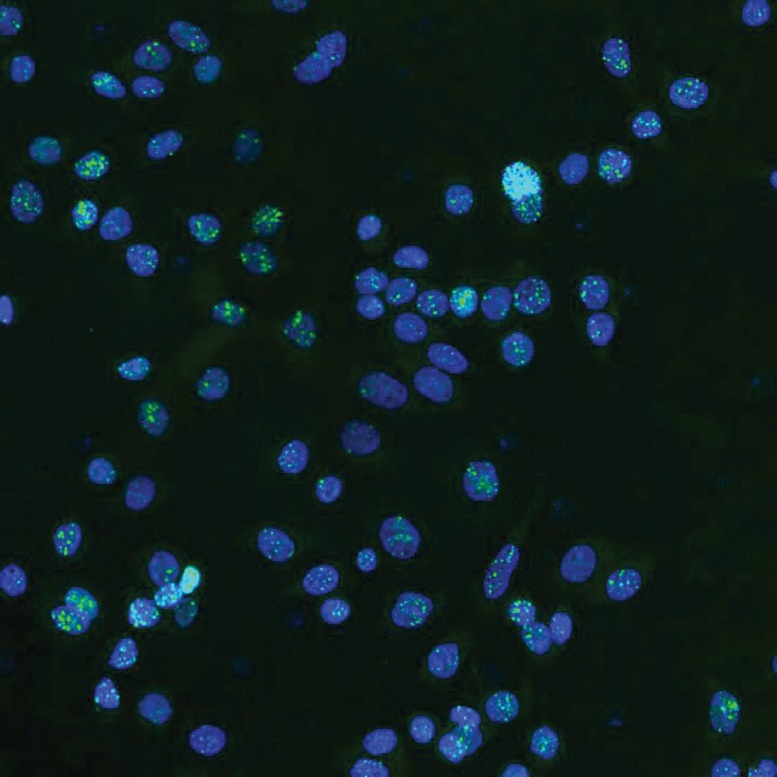
با زباله DNA سرطان را درمان کنید

با زباله DNA سرطان را درمان کنید
به گزارش خبرنگار گروه علم و فناوری خبرگزاری برنا؛ این مطالعه جهشهایی را در این مناطق یافت که با ۱۲ نوع مختلف سرطان مرتبط است. این جهشها در مکانهای اتصال پروتئین CTCF رخ میدهد که برای حفظ ساختار سه بعدی ژنوم حیاتی است. اختلال در این سایتها ممکن است به توسعه سرطان کمک کند. یافتهها نشان میدهد که یک رویکرد جهانی بالقوه برای درمان سرطان وجود دارد که این جهشهای رایج را در سرطانهای مختلف هدف قرار میدهد.
محققان موسسه گاروان از هوش مصنوعی برای شناسایی عناصر بالقوه سرطان زا در مناطق "زباله" DNA استفاده کرده اند و راه را برای روشهای نوآورانه در تشخیص و درمان هموار کرده اند.
بر اساس یک مطالعه جدید از موسسه تحقیقات پزشکی گاروان، DNA غیر کدگذاری-که ۹۸ درصد از ژنوم ما را تشکیل میدهد و حاوی دستورالعملهایی برای ساخت پروتئین نیست، ممکن است کلید تشخیص و درمانهای جدید سرطان را در بر بگیرد. یافتههای منتشر شده در مجله Nucleic Acids Research، جهشهایی را در مناطق قبلا نادیده گرفته شده ژنوم نشان میدهد که ممکن است به تشکیل و پیشرفت حداقل ۱۲ سرطان مختلف، از جمله سرطان پروستات، پستان و روده بزرگ کمک کند.
این کشف میتواند منجر به تشخیص زودهنگام و درمانهای جدید موثر برای بسیاری از انواع سرطان شود.
آماندا خوری، افسر تحقیق در گاروان و نویسنده مشترک این مطالعه گفت: DNA غیر کدگذاری شده زمانی به دلیل عدم عملکرد ظاهری آن به عنوان "DNA ناخواسته " رد شد. تحقیقات ما جهشهایی را در این مناطق DNA پیدا کرده است که میتواند یک رویکرد کاملا جدید و جهانی برای درمان سرطان را باز کند.
بررسی "لنگر" DNA در سرطان مختل شده است
محققان بر جهشهایی که بر مکانهای اتصال به پروتئین به نام CTCF تأثیر میگذارد، تمرکز کردند که به تا کردن رشتههای طولانی DNA به شکلهای خاص کمک میکند. در کار قبلی خود، آنها دریافتند که این مکانهای اتصال بخشهای دور DNA را به هم نزدیک میکنند و ساختارهای سه بعدی را تشکیل میدهند که کنترل میکنند کدام ژنها روشن یا خاموش میشوند.
خوری گفت: ما قبلا زیر مجموعهای از سایتهای اتصال CTCF را شناسایی کرده بودیم که "مستمر" هستند، یعنی آنها مانند لنگر در ژنوم عمل میکنند و در انواع مختلف سلولها وجود دارند. ما فرض کردیم که اگر این لنگرها معیوب شوند، میتواند سازماندهی سه بعدی طبیعی ژنوم را مختل کند و به سرطان کمک کند.
برای آزمایش این، محققان یک ابزار جدید پیشرفته یادگیری ماشین (AI) به نام CTCF-INSITE را توسعه دادند که از ویژگیهای ژنومیک و اپی ژنومیک برای پیش بینی اینکه کدام سایتهای CTCF احتمالا لنگر مداوم در مجموع ۱۲ نوع سرطان هستند، استفاده میکرد. سپس آنها بیش از ۳۰۰۰ نمونه تومور از بیماران مبتلا به ۱۲ نوع سرطان را که از پایگاه داده کنسرسیوم ژنوم بین المللی در دسترس است، ارزیابی کردند و دریافتند که لنگرهای مداوم غنی از جهش هستند.
ونهان چن، نویسنده اول این مطالعه گفت: با استفاده از ابزار یادگیری ماشین ما، ما سایتهای اتصال ctcf مداوم را در ۱۲ نوع مختلف سرطان شناسایی کردیم. به طور قابل توجهی، ما دریافتیم که هر نمونه سرطان حداقل یک جهش در یک سایت اتصال CTCF مداوم دارد. این تحقیق تایید کرد که سایتهای اتصال CTCF مداوم" نقاط داغ جهش " در سرطان هستند. ما فکر میکنیم این جهشها به سلولهای سرطانی مزیت بقا میدهد و به آنها اجازه میدهد تا تکثیر و گسترش یابند.
به سوی یک رویکرد جهانی درمان سرطان
این یافتهها میتواند پیامدهای گستردهای برای درک و درمان انواع مختلف سرطان داشته باشد. پروفسور سوزان کلارک، رئیس آزمایشگاه اپی ژنتیک سرطان در گاروان و نویسنده اصلی این مطالعه گفت: بیشتر درمانهای جدید سرطان باید با دقت به جهشهای خاصی که همیشه در میان انواع مختلف تومور رایج نیست، هدف قرار گیرند، اما از آنجا که این لنگرهای CTCF در چندین نوع مختلف سرطان جهش یافته اند، ما امکان توسعه رویکردهایی را که میتواند برای سرطانهای متعدد موثر باشد، باز میکنیم.
محققان در حال حاضر در حال برنامه ریزی برای آزمایشهای گسترده با استفاده از ویرایش ژن CRISPR برای بررسی چگونگی این جهشهای لنگر، ژنوم سه بعدی را مختل میکنند و به طور بالقوه رشد سرطان را ترویج میدهند.
کلارک گفت: اکنون که ما آنچه را که به اعتقاد ما لنگرهای حیاتی ژنوم است کشف کرده ایم و نشان داده ایم که آنها برای حفظ هموستاز معماری ژنوم مهم هستند، منطقی است که این جهشهای غیر کدگذاری DNA این هموستاز را در سلول سرطانی مختل میکند- فرضیهای که ما هنگام ویرایش آنها آزمایش خواهیم کرد. با مشاهده تاثیر پایین جریان، ما امیدواریم ژنهای کلیدی یا مسیرهای ژن را که تحت تاثیر جهشها قرار میگیرند، شناسایی کنیم، که میتواند به عنوان نشانگر برای تشخیص زودهنگام سرطان یا اهداف برای درمانهای جدید عمل کند.
او گفت: یافتن این سرنخهایی که در حجم زیادی از دادهها پنهان شده اند، نمونهای قدرتمند از چگونگی تقویت هوش مصنوعی در تحقیقات پزشکی است. این یک مرز کاملا جدید در مطالعه سرطان است و ما هیجان زده هستیم که آن را بیشتر کشف کنیم.
انتهای پیام/




